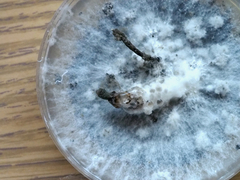
Xylaria feejeensis

Xylaria feejeensis: taxon details and analytics
- Domain
- Kingdom
- Fungi
- Phylum
- Ascomycota
- Class
- Sordariomycetes
- Order
- Xylariales
- Family
- Xylariaceae
- Genus
- Xylaria
- Species
- Xylaria feejeensis
- Scientific Name
- Xylaria feejeensis
Summary description from Wikipedia:
Xylaria feejeensis in languages:
- Chinese
- 斐濟炭角菌
Images from inaturalist.org observations:
We recommend you sign up for this excellent, free service.
Parent Taxon
Sibling Taxa
- Fissilis
- Multiplex
- Polymorpha
- Pseudoxylaria
- Xylaria acuta
- Xylaria adscendens
- Xylaria aemulans
- Xylaria alata
- Xylaria albisquamula
- Xylaria alboaerolata
- Xylaria alboareolata
- Xylaria allantoidea
- Xylaria amphithele
- Xylaria anisopleura
- Xylaria apeibae
- Xylaria apiculata
- Xylaria arbuscula
- Xylaria aristata
- Xylaria atrosphaerica
- Xylaria avellana
- Xylaria bambooensis
- Xylaria bambusicola
- Xylaria berkeleyi
- Xylaria berteroi
- Xylaria bipindensis
- Xylaria boergesenii
- Xylaria brachiata
- Xylaria brasiliensis
- Xylaria brevipes
- Xylaria bulbosa
- Xylaria carpophila
- Xylaria castilloi
- Xylaria castorea
- Xylaria chordiformis
- Xylaria cinerea
- Xylaria clavata
- Xylaria claviceps
- Xylaria clusiae
- Xylaria coccophora
- Xylaria comosa
- Xylaria compuncta
- Xylaria conocephala
- Xylaria coprinicola
- Xylaria cordovensis
- Xylaria corniculata
- Xylaria corniformis
- Xylaria cornu-damae
- Xylaria cranioides
- Xylaria cristata
- Xylaria cubensis
- Xylaria culicicephala
- Xylaria culleniae
- Xylaria cuneata
- Xylaria curta
- Xylaria delicatula
- Xylaria dichotoma
- Xylaria digitata
- Xylaria diminuta
- Xylaria duranii
- Xylaria ellisii
- Xylaria enterogena
- Xylaria enteroleuca
- Xylaria eugeniae
- Xylaria feejeensis
- Xylaria filiformis
- Xylaria finismundoensis
- Xylaria fissilis
- Xylaria flabelliformis
- Xylaria fockei
- Xylaria friesii
- Xylaria frustulosa
- Xylaria furcata
- Xylaria globosa
- Xylaria gracillima
- Xylaria grammica
- Xylaria guazumae
- Xylaria guepinii
- Xylaria guianensis
- Xylaria heliscus
- Xylaria hippotrichoides
- Xylaria hyperythra
- Xylaria hypoxylon
- Xylaria ianthinovelutina
- Xylaria inaequalis
- Xylaria jaliscoensis
- Xylaria juniperus
- Xylaria juruensis
- Xylaria karyophthora
- Xylaria kegeliana
- Xylaria laevis
- Xylaria lancea
- Xylaria liquidambar
- Xylaria longiana
- Xylaria longipes
- Xylaria luteostromata
- Xylaria luxurians
- Xylaria magniannulata
- Xylaria magnoliae
- Xylaria maitlandii
- Xylaria mali
- Xylaria melanaxis
- Xylaria melanura
- Xylaria meliacearum
- Xylaria mellissii
- Xylaria mexicana
- Xylaria michoacana
- Xylaria microceras
- Xylaria multiplex
- Xylaria muscula
- Xylaria musooriensis
- Xylaria myosurus
- Xylaria nigrescens
- Xylaria obovata
- Xylaria olobapha
- Xylaria ophiopoda
- Xylaria oxyacanthae
- Xylaria pallida
- Xylaria palmicola
- Xylaria penicilliopsis
- Xylaria perezsilvae
- Xylaria persicaria
- Xylaria phosphorea
- Xylaria phyllocharis
- Xylaria pilaeformis
- Xylaria poitei
- Xylaria polymorpha
- Xylaria primorskensis
- Xylaria psamathos
- Xylaria psidii
- Xylaria putaminum
- Xylaria quercinophila
- Xylaria readeri
- Xylaria rhizomorpha
- Xylaria rhopaloides
- Xylaria rhytidophloea
- Xylaria rickii
- Xylaria rohrensis
- Xylaria scabriclavula
- Xylaria schreuderiana
- Xylaria schweinitzii
- Xylaria scruposa
- Xylaria sicula
- Xylaria squamulosa
- Xylaria stilboidea
- Xylaria striata
- Xylaria subcoccophora
- Xylaria subterranea
- Xylaria subtorulosa
- Xylaria tabacina
- Xylaria telfairii
- Xylaria terricola
- Xylaria theissenii
- Xylaria tuberiformis
- Xylaria tuberoides
- Xylaria tucumanensis
- Xylaria uniapiculata
- Xylaria vasconica
- Xylaria violaceorosea
- Xylaria wellingtonensis
- Xylaria xylarioides
- Xylaria zealandica